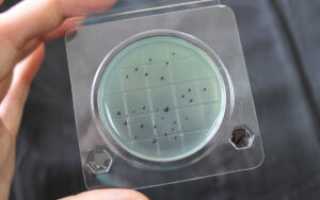

Описание
Микробиологические экспресс-тесты “Петритест” используются во всех областях пищевой промышленности.
Экспресс-тесты предназначены для выявления таких микробиологических показателей как:
- Бактерии группы кишечной палочки
- Дрожжи/грибы
- Бактерии Сальмонеллы
- Бактерии Стафилококка
- Определение общего микробного числа (КМАФАнМ)
“Петритест” выполнен в форме подложки (пластиковой чашки Петри) с готовой питательной модифицированной средой на основе агара.
Это позволяет использовать тест сразу после вскрытия без процессов дополнительной пробоподготовки.
Преимущества экспресс-тестов для микробиологии “Петритест”
В рамках контроля микробиологии производства и продуктов, наряду с другими, определяют и бактерии группы кишечных палочек (БГКП), являющихся возбудителями пищевых интоксикаций. Определяют кишечную палочку и для санитарно-гигиенической оценки чистоты воды и поверхностей трубопроводов, оборудования, инвентаря, тары, рабочих поверхностей предприятий, а также чистоты рук персонала.
Имеются в виду одноклеточные грибы, которые называются дрожжи, и гифальные грибы, тело которых состоит из переплетающихся ветвящихся нитей (гиф), то есть плесень.
Грибы получили широкое распространение в пищевой промышленности. Так, дрожжи вызывают брожение и их с успехом применяют в пивоварении и квасоварении, хлебопечении и т.д. Плесени же используют для изготовления сыров, производстве лимонной кислоты, виноделии и пр.
Однако ни в коем случае нельзя недооценивать опасность грибов для здоровья человека. Многие плесневые грибы вырабатывают микотоксины – ядовитые вещества, ряд сапрофитов (грибы, питающиеся мертвыми органическими веществами) являются причиной заболевания человека и животных – микозов, аспергиллезов и др. Также некоторые виды плесени могут вызвать аллергические реакции. Широко известно негативное влияние грибов и в сельском хозяйстве – плесень заводится в зерне и кормах для животных.
В настоящее время существует несколько методик для определения грибов в продуктах питания. Они различаются как по питательным средам, так и по способам посева и времени инкубации. При изучении продуктов, куда специально добавляют плесень или дрожжи в процессе изготовления, необходимо определить соответствие данных показателей имеющимся нормативам.
Основная роль в возникновении пищевых сальмонеллезов принадлежит мясу, субпродуктам, молоку и яйцам. Обсеменение мяса сальмонеллами происходит как прижизненно, так и после убоя – при неправильной обработке туш или обработке не продезинфицированными инструментами или человеком – носителем бактерий. Характерно, что в фарше сальмонеллы развиваются быстрее, чем в цельных кусках мяса. К сожалению, при тепловой обработке приготовленных из фарша продуктов очень трудно добиться их полной стерильности.
Молоко может быть инфицировано бактериями при доении коров и обработке молока. Опасность заключается в том, что сальмонеллы очень долго сохраняются в молочных продуктах: в сливочном масле более 4-х месяцев (130 суток), а в некоторых видах сыра до года. В свою очередь, яйца обсеменяются сальмонеллами как экзогенным, так и эндогенным путем.
Экспресс-тест на стафилококки
Одни из самых распространенных бактерий – стафилококки. Эти бактерии вырабатывают энтеротоксины, которые могут вызвать острые инфекции и заболевания, серьезные гнойные воспалительные процессы практически во всех органах и тканях.
На пищевом предприятии источниками обсеменения пищевых продуктов являются люди, причем не только с поражениями кожи (ожоги, порезы, гнойники и пр.) или страдающие ОРВИ. Было доказано, что и здоровые носители болезнетворных бактерий могут инфицировать продукты. Скорость образования опасных энтеротоксинов зависит от температуры и состава пищевых продуктов. Стафилококки могут быть как в белковых продуктах, так и в углеводистых. Так что стафилококковые токсикозы легко могут возникнуть и в молочных продуктах, и в кондитерских, и в мясных (особенно опасен фарш), и в салатах.
Анализы на ОМЧ (общее микробное число) проводятся на всех пищевых производствах. Это позволяет быстро обнаружить очаги распространения патогенных микроорганизмов, их степень размножения, и впоследствии принять все меры для профилактики развития посторонней микрофлоры либо для ее уничтожения.
Поставляются упаковками по 10 готовых подложек. Цена указана за упаковку.
БГКП – это колиморфные бактерии, которые относятся к семейству энтеробактерий и используются в качестве определителя фекальной контаминации. Они имеют принципиальные отличия от стафилококков – данная категория представлена разнородными микроорганизмами, к которым относятся представители родов Citrobacter, Escherichia, Enterobacter и другие бациллы. Их объединяет схожесть с главной представительницей флоры кишечника – кишечной палочкой. Несмотря на некоторое сходство, на микробиологических питательных средах они способствуют образованию колонии другого цвета и вида.
Эшерихии имеет отличия от цитробактера и энтеробактера и заключаются они в свойствах размножения. Данная особенность позволяет определить, как давно произошло микробное обсеменение. Если при проверке обнаруживается присутствие эшерихий, это может свидетельствовать о том, что загрязнение БГКП было произведено недавно. Цитробактер или энтеробактер указывают на то, что с момента образования бактерий прошло несколько недель.
Важность проведения регулярных проверок на наличие микроорганизмов
Правила, направленные на создание регламентирующих документов, в том числе МУ и СанПиН, разрабатывались на основании данных проводимых исследований микроорганизмов. Они необходимы для определения частоты проверок, рекомендованных методик, объектов, которые подвергаются более пристальному контролю. Учитывая важность обеспечения безопасности населения, легко объяснить скрупулезность действий в СанПиН и МУ.
Фекальные микроорганизмы, которые попадают в окружающую среду из желудочно-кишечного тракта, относятся к одной из наиболее распространенных категорий. Второй категорией является оральная – она представлена микроорганизмами, которые обитают в полости рта. Большинство БГКП по признакам схоже с Escherichia coli – это распространенный представитель группы в связи с легкостью дифференцирования. Также она отличается быстрейшими темпами роста и поэтому служит определителем того, что загрязнение произошло недавно.
В чем опасность БГКП для организма?
БГКП может вызвать острую кишечную инфекцию, проявляемую в виде отравления. Путем распространения заболевания может быть вода, которой моют посуду после употребления пищи, сама посуда или еда. Компоненты постоянно контактируют между собой, за счет чего производится осеменение и последующая передача к здоровому человеку.
Проведение анализа
Следует помнить, что не во всех случаях возбудитель может стать возбудителем заболеваний – подобное происходит при превышении предельно допустимой концентрации микроорганизмов. В нормативных документах указывается безопасный уровень, превышение которого и может вызвать различные осложнения. Обнаружение возбудителей осуществляется при помощи материалов, которые могут потенциально содержать бактерии или контактировать с больным.
Определение безопасности может проводиться в трех направлениях:
- анализ на наличие бактерий;
- установление количества;
- диагностика биохимических характеристик.
Первые варианты используются повсеместно, третий – при необходимости детального изучения возбудителя. В зависимости от целей исследования процедуры, которые необходимы для анализа, могут отличаться.
- Для выявления бактерий потребуется осуществить посев образца в пробирку, в которой будет находиться богатая на лактозу среда. Взятые образцы выдерживаются при температуре 37 C до 48 часов. В подобных условиях производится выращивание колоний группы кишечной палочки.
- Для определения числа бактерий такой же объем материала наносится на специальные чашки Петри. После проведения процедуры инкубации в термостате происходит рост колонии – в данном случае клетки получают название колониеобразующих единиц. С помощью подсчета КОЕ можно определить количество бактерий в 1 л.
- Биохимические свойства устанавливаются при помощи пробирок со средой Гиса. Добавляя необходимые компоненты, можно определить уровень сахаролитической активности микроорганизмов.
В отдельных случаях может использоваться ускоренный метод выявления бактерий группы кишечных палочек. После первичной обработки образца отделяется небольшой фрагмент, который помещается в стерильную пробирку вместе с комочком стерильной фильтровальной бумаги. Далее в емкость наливается среда ХБ или Хейфеца. Пробирка укладывается в термостат на период от 12 до 14 часов. В случае, если в пробе имеются БГКП, среда меняет свой цвет.
Особенности отбора проб
Забор материалов для исследования производится на основании методических указаний и стандартов для каждого продукта. Смыв с рук обследуемого производится при помощи увлажненного средой ватного тампона. Чтобы добиться более точной оценки, требуется протереть каждую ладонь и пальцы не менее пяти раз, также не забыв о межпальцевых промежутках.
При изучении стаканов протирается внутренняя поверхность и верхний наружный край. Во время взятия смывов с санитарной одежды выборочно протирается четыре 25-сантиметровые – чаще всего это касается нижней части рукавов, а также фрагментов передних пол. Отметим, что стерильные тампоны заготавливаются лабораторией заблаговременно, устанавливаясь в пробирки с ватными пробками.
Далее отобранная проба отправляется в центр, помещаясь перед этим в герметично закрытую емкость. При перевозке помимо оптимальных условий хранения, которые препятствуют повреждению образцов, также важно обеспечивать низкий уровень температуры. В связи с этим не рекомендуется осуществлять забор образцов самостоятельно – этим должны заниматься специалисты. В лаборатории БГКП из емкости укладывается в раствор с использованием вибрирующего аппарата. Для проведения исследований достаточно 1 см³ жидкости.
В каких случаях нужно проводить исследования?
Проверка продуктов, а также одежды, посуды и оборудования чаще всего производится с целью оценки санитарно-гигиенического состояния организаций общественного питания, пищевой промышленности, а также больниц, лечено-профилактических и детских учреждений. В зависимости от цели исследования может проверяться наличие БГКП, их тип и общее число.
Вода является неотъемлемой составляющей всех живых систем. В среднем, человек потребляет 2,5 литра воды в день. Наряду с полезным кальцием, магнием и калием вода несет в себе и вредные для здоровья человека элементы, такие как нитраты, нитриты, кадмий и тому подобное. Характеристики употребляемой нами жидкости определяют качество и продолжительность жизни. Согласно докладу Всемирной организации здравоохранения (WHO, 2007), около 1,1 миллиарда человек не имеют доступа к безопасным источникам водоснабжения, а около 2 миллиона человек ежегодно умирают от заболеваний, передающихся через питьевую воду. Тошнота и диарея – не самое опасное, что вызывают микроорганизмы. Бактерии и вирусы в прямом смысле могут отравлять нашу жизнь, вызывая болезни с летальным исходом (например, Clostridium botulinum – возбудитель ботулизма) или опосредовано приводя к смертельным случаям (Helicobacter pylori – возможная причина рака ЖКТ). В Российской Федерации состояние воды регламентируются несколькими нормативами в зависимости от предназначения (смотреть таблицу).
| Показатель | Природная вода 1 | Вода бассейнов 2 | Нецентр. водоснаб. 3 | Центр. водоснаб. 4 | Бутилированная вода 5 |
|---|---|---|---|---|---|
| Общая микробная численность (ОМЧ), КОЕ / 1 мл | – | – | не более 100 | не более 50 | не более 20 |
| Общие колиформные бактерии (ОКБ), КОЕ / 100 мл | не более 1 | отсутствие в 100 мл | отсутствие в 100 мл | отсутствие в 300 мл | |
| Термо-толерантные колиформные бактерии (ТКБ), КОЕ / 100 мл | не более 100 | отсутствие в 100 мл | отсутствие в 100 мл | отсутствие в 100 мл | отсутствие в 300 мл |
| Колифаги, БОЕ / 100 мл | не более 10 | отсутствие в 100 мл | отсутствие в 100 мл | отсутствие в 100 мл | отсутствие в 1000 мл |
| Споры сульфит-редукторов | – | – | – | отсутствие в 20 мл | отсутствие в 20 мл |
| Возбудители кишечных инфекций | отсутствие в 1000 мл | отсутствие в 1000 мл | отсутствие в 1000 мл | отсутствие в 1000 мл | отсутствие в 1000 мл |
| Синегнойная палочка (Pseudomonas aeruginosa) | – | отсутствие в 100 мл | – | – | отсутствие в 1000 мл |
| Золотистый стафилококк (Staphylococcus aureus) | – | отсутствие в 100 мл | – | – | – |
Оценка качества по микробиологическим показателям сводится к определению в объекте доли микроорганизмов, связанных с человеком и его продуктами жизнедеятельности.
Прежде всего, определим единицы измерения количества микробов. КОЕ/мл (колониеобразующие единицы) – количество жизнеспособных микробных клеток в миллилитре. Если производится оценка вирусных частиц в среде, то указывается БОЕ/мл (бляшкообразующие единицы) – количество вирусных частиц в миллилитре.
Общие показатели
Выявляет бактерии, потенциально способные причинить вред здоровью. Этот показатель достаточно информативен, так как высокая ОМЧ является индикатором загрязнения органическими соединениями (например, содержащихся в фекалиях) и различными формами азота. С другой стороны, в ОМЧ входят как опасные бактерии (например, высокопатогенный штамм кишечной палочки Escherіchіa colі), так и практически безвредные и повсеместно встречаемые сенные палочки (Bacillus subtillis).
Группу ОКБ формируют бактерии семейства Enterobacteriacea (Citrobacter, Enterobacter, Klebsiella). Многие представители этой группы относятся к нормальной микрофлоре желудка, поэтому превышение ОКБ может говорить о возможном фекальном загрязнении, связанном с деятельностью человека. Однако в данной группе могут встречаться и свободноживущие микробы, которые не представляют опасности для здоровья.
ТКБ – более достоверный индикатор загрязнения продуктами жизнедеятельности. Этот показатель свидетельствует о свежем фекальном загрязнении. В большинстве случаев в этой группе обнаруживается кишечная палочка Escherіchіa colі.
Колифаги являются вирусами палочки Escherichia coli и рассматриваются эпидемиологами как более чувствительный метод определения загрязнения жидкости микроорганизмами группы кишечной палочки. Вирусные частицы более устойчивы к окружающей среде, чем бактерии, в которых они обитают, поэтому этот показатель качества служит достоверной меткой давнего фекального загрязнения. Содержание колифагов свидетельствует о наличии опасных для человека энтеровирусов в воде.
Рекомендуется проводить исследование этой характеристики в случае, если ранее источник не был проверен, а также для оценки эффективности методов дезинфекции источников и систем подачи-распределения воды.
Спорообразующие клостридии (Clostridium botulinum, Clostridium perfringens, Clostridium tetani) являются дополнительным микробиологическим показателем фекального загрязнения. Клостридии встречаются в кишечнике, однако при попадании в организм в большом количестве могут вызывать пищевые отравления и смертельные заболевания, в том числе, ботулизм. В отличие от относительно неустойчивых ОКБ и ТКБ, споры клостридий могут сохраняться долгое время, поэтому этот микробиологический показатель, как и колифаги, свидетельствует о наличии давнего загрязнения. Относительно высокая устойчивость позволяет использовать споры в качестве индикатора эффективности проведения водоподготовки (хлорирования, озонирования и т.п.).
Определение этого микробиологического показателя качества воды рекомендуется проводить при наличии посторонних запахов и образовании чёрного налёта на трубах, а также для оценки эффективности методов дезинфекции источников и систем подачи-распределения жидкости.
Pseudomonas aeruginosa – распространённый организм, который встречается практически во всех средах, в т. ч. входит в состав микрофлоры кожи. Однако при снижении иммунитета человека и высоком содержании в воде синегнойная палочка может вызывать серьёзные заболевания, поражая лёгкие и почки и приводя к сепсису. Присутствие Pseudomonas aeruginosa в бассейне или ванне является основанием для полной замены содержимого резервуара. Особенность синегнойной палочки – её чрезвычайная устойчивость к нагреванию, дезинфицирующим средствам и антибиотикам.
Staphylococcus aureus – тесно связанная с человеком бактерия, которая в основном образует колонии на коже, половых органах, респираторном и желудочно-кишечном трактах. Как и синегнойная палочка, золотистый стафилококк встречается у здоровых людей, однако может вызвать развитие болезни при ослаблении иммунитета.
В действующих нормативных документах не прописаны конкретные возбудители кишечных инфекций. В эту группу входят микроорганизмы, заражение которыми происходит через жидкие среды (Escherichia, Shigella, Vibrio, Salmonella). Процесс определения этого параметра трудоёмок и требует специальной квалификации микробиолога.
Микробиологические показатели качества воды, не регулируемые СанПиН
Развитие и удешевление технологий и новых методов приводит, с одной стороны, к расширению контролируемых параметров, с другой, к выбору более конкретных микроорганизмов-показателей. Например, руководство ВОЗ рекомендует использовать в качестве индикатора фекального загрязнения наличие кишечной палочки (Escherіchіa colі), а не ОКБ и ТКБ. В странах ЕС помимо палочки определяют наличие энтерококков – специфичной группы микроорганизмов обитателей кишечника человека. Ниже приведены группы микроорганизмов, которые имеют индикаторное значение при оценке микробиологического качества воды.
Enterococcus spp. – широкая группа микроорганизмов, проживающая в кишечнике человека. Наряду с золотистым стафилококком энтерококки являются причиной внутрибольничных инфекций, вызывают у человека (менингит, эндокардит). Ввиду более высокой устойчивости этих микроорганизмов к засолению и температуре, по сравнению с ТКБ, энтерококки – более надежный индикатор фекального загрязнения морей и солёных озёр. Согласно нормативу ЕС, эта группа не должна обнаруживаться в 250 мл. Согласно законодательству США, при превышении содержания Enterococcus spp. 35 КОЕ / 100 мл вводится запрет на купание людей.
К условно-патогенным дрожжам и микромицетам (плесени) относят большую неоднородную группу грибных организмов. В неё входят Candida albicans и Cryptococcus neoformans, которые вызывают оппортунистические заболевания, в т. ч. грибковые заболевания кожи и молочницу. Другие организмы-микромицеты (Cladosporium cladosporioides, Aspergillus niger) усиливают аллергические реакции, а иногда вызывают их. Особенно опасны плесневые грибы (Penicillium spp., Aspergillus spp., Fusariam spp., Alternaria spp. and Claviceps spp), образующие канцерогенные микотоксины (патулин, афлотоксин). Исследователи из Европейского союза пришли к выводу, что водопроводная вода не является распространителем микотоксинов, однако в стоячих источниках (например, накопительных резервуарах) могут создаться условия для благоприятного развития грибов. В некоторых странах ЕС содержание грибов строго регламентируется, например, в Швеции в питьевой воде их не может быть более 100 КОЕ / 100 мл.
Микроорганизмы, содержащие зелёный пигмент хлорофилл – обитатели богатых питательными элементами стоячих водоемов. Сами микроорганизмы не заражают человека, но синтезируют и выделяют в среду цианотоксины, вызывающие поражение внутренних органов млекопитающих: гепатотоксины (Microcystis, Anabaena, Oscillatoria, Nodularia, Nostoc, Cylindrospermopsis и Umezakia), нейротоксины (Aphanizomenon и Oscilatoria), почечные токсины (Cylindroapermopsis raciborski).
Таким образом, микробиологические показатели качества воды отражают несколько важных показателей:
- Общее загрязнение микроорганизмами источника воды (ОМЧ).
- Наличие фекального загрязнения и продуктов жизнедеятельности (ОКБ, ТКБ, колифаги, сульфитредукторы, энтерококки).
- Возможное наличие энтеровирусов (колифаги).
- Наличие потенциально опасных микроорганизмов (золотистый стафилококк, синегнойная палочка, условно-патогенные дрожжи, энтерококки, сульфитредукторы).
- Наличие потенциальных продуцентов микотоксинов и цианотоксинов (грибы и цианобактерии).
- Наличие патогенных микроорганизмов (Shigella, Vibrio, Salmonella).